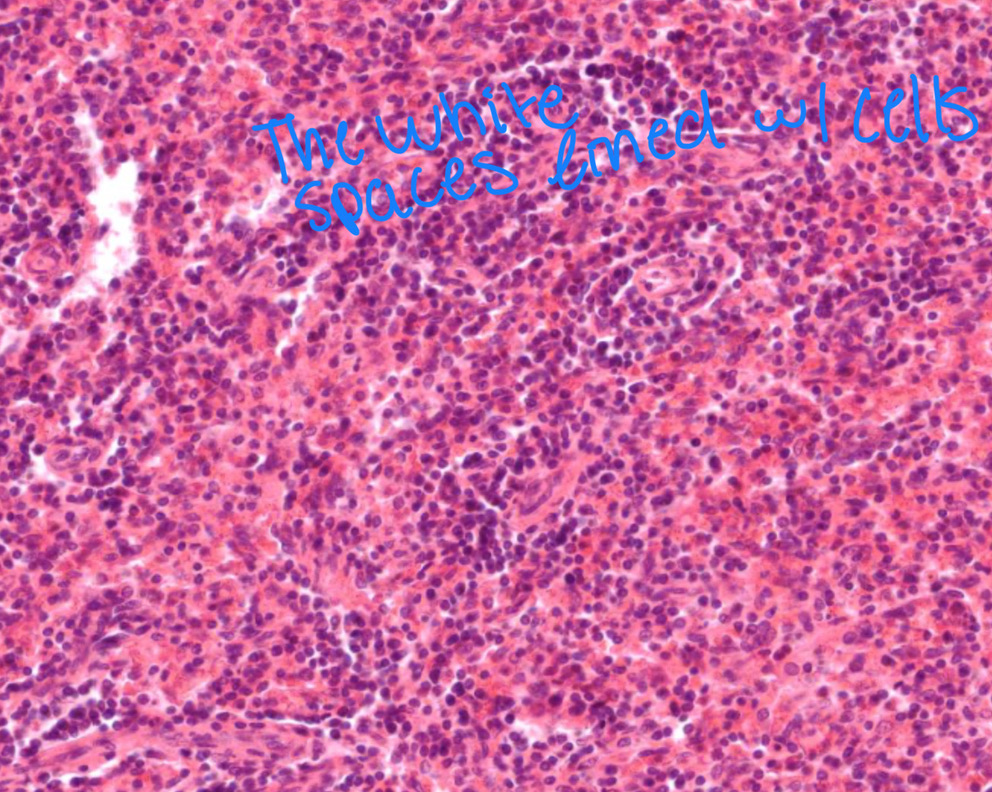
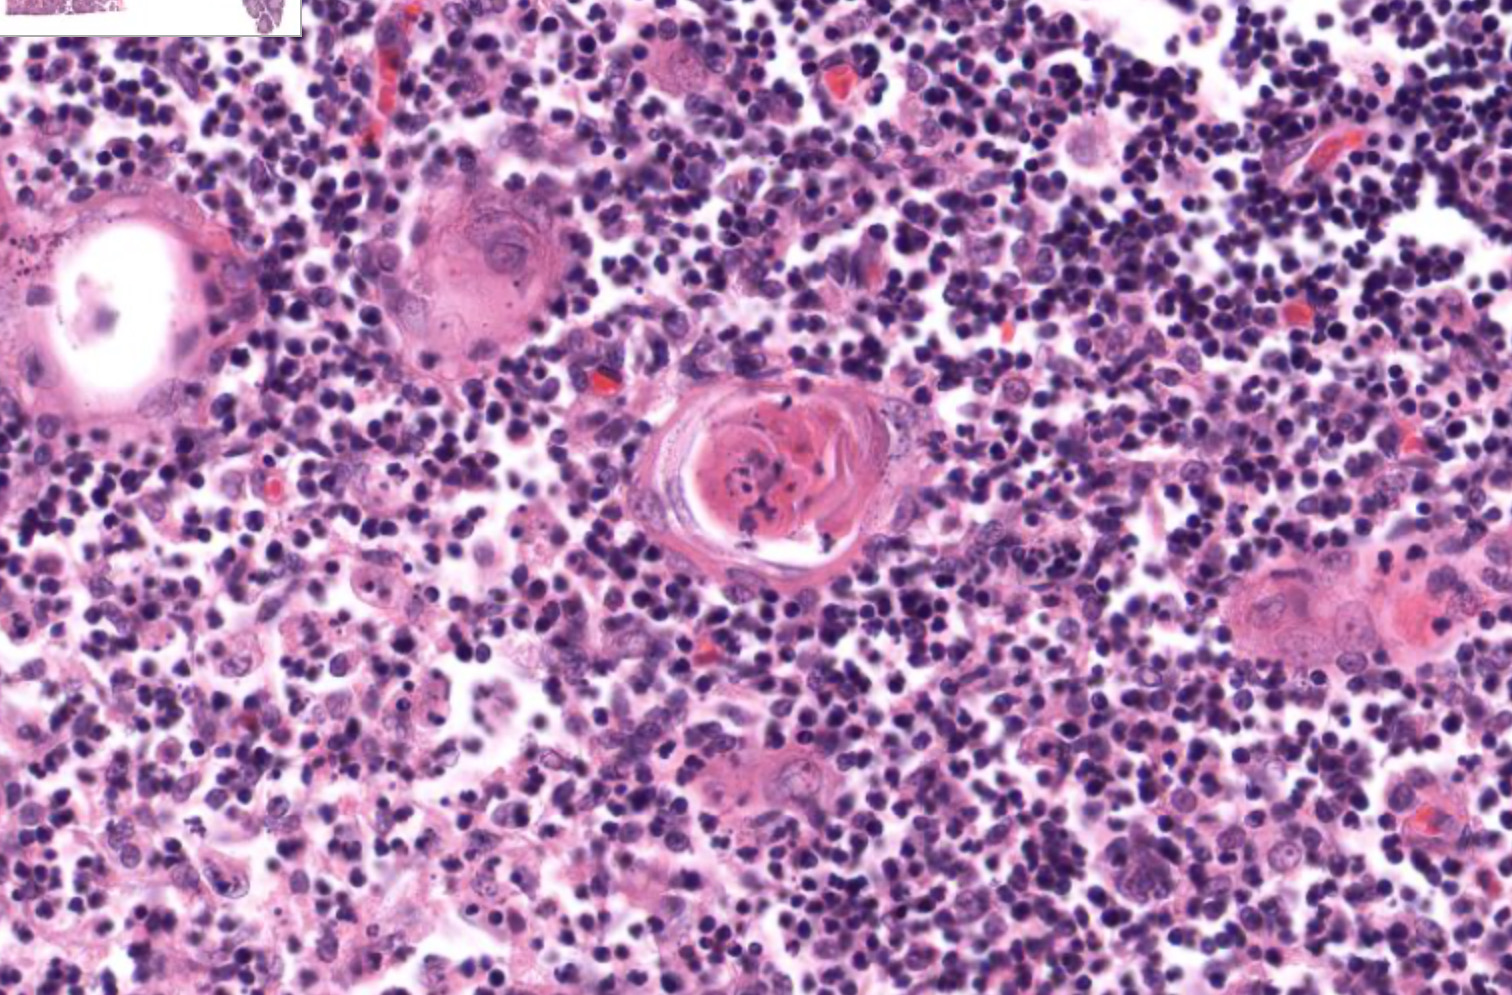

exercise 23/24 lymphatic and respiratory system
1/137
There's no tags or description
Looks like no tags are added yet.
Name | Mastery | Learn | Test | Matching | Spaced |
|---|
No study sessions yet.
138 Terms

Pharyngeal tonsil

Palatine tonsil

lingual tonsil

spleen

thymus

sphenoidal sinus

frontal sinus

ethmoid sinus

maxillary sinus

frontal sinus

sphenoidal sinus

left jugular trunk

cervical lymph nodes

axillary lymph nodes

inguinal lymph nodes

left subclavian trunk

left lumbar trunk

right lumbar trunk

right subclavian trunk

right jugular trunk

intestinal trunk

cisterna chyl

right lymphatic duct

lymph node

cortex

lymphatic nodule

medulla

lymphatic nodule

germinal center

white pulp of spleen

red pulp of spleen

each individual dot
B lymphocyte
the white spaces lined with cells
splenic sinus

each individual dot
thymocyte

thymus

spleen
Hassall’s corpuscle of thymus

Superior nasal concha

middle nasal concha

inferior nasal concha

superior nasal meatus

middle nasal meatus

inferior nasal meatus

septal cartilage

vomer

perpendicular plate

the hole
external nare

whole section (BONE)
nasal septum

whole section (AIR)
paranasal sinus

hard palate

soft palate

oropharynx

nasopharynx

laryngopharynx

whole section
nasal cavity

nasopharynx

oropharynx

laryngopharynx

larynx

trachea

uvula

whole section
phraynx

auditory tube

esophagus

hyoid bone

vestibular folds

vocal cord

epiglottis

thyroid cartilage

laryngeal prominence

cricoid cartilage

hyoid bone

vocal cord

vestibular fold

epiglottis

thyroid cartilage

laryngeal prominence

cricoid cartilage

arytenoid cartilage

corniculate cartilage

cuneiform cartilage

trachea

larynx

trachea

trachealis

pseudostratified ciliated columnar epithelium

lamina propria

hyaline cartilage

mucosa

behind cartilage ring
adventitious

carina

trachea

diaphragm

diaphragm

lung

lung

bronchus

primary bronchus

secondary bronchus

tertiary bronchus